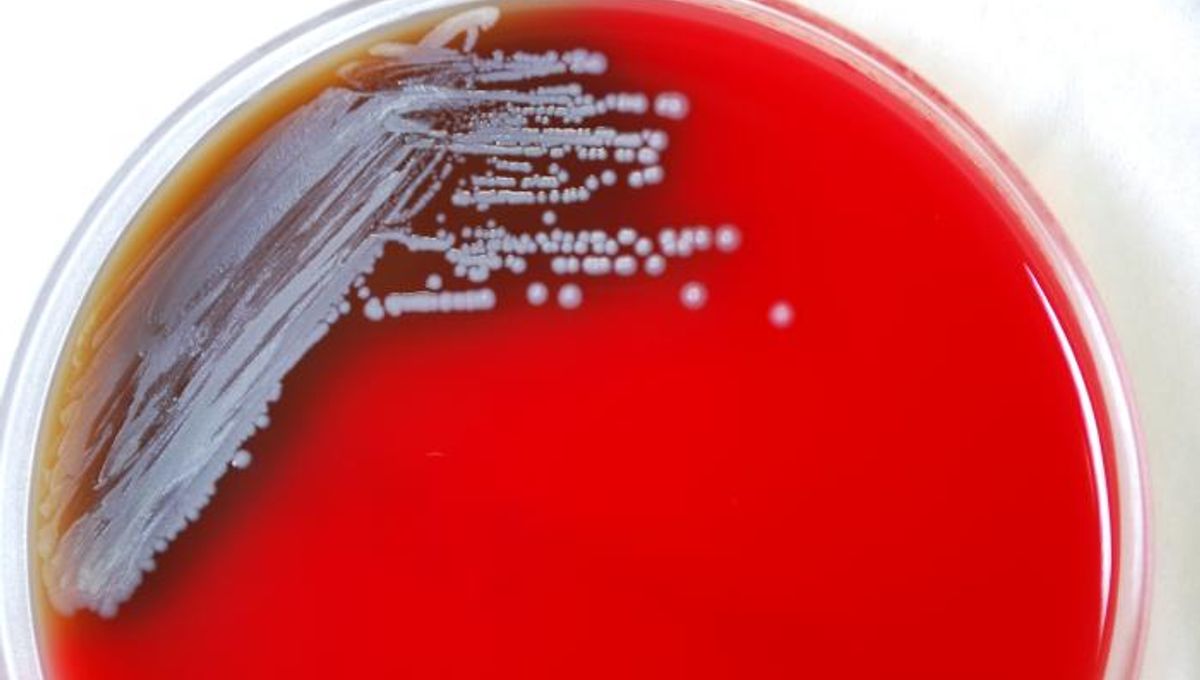

Deadly Bacteria Found In Mainland Us Soil For First Time Already Linked To Two Cases
Executive Summary
Discover comprehensive information about Deadly Bacteria Found In Mainland Us Soil For First Time Already Linked To Two Cases. This page aggregates 7 curated sources, 8 visual resources, and 2 related topics to give you a complete overview.
People searching for "Deadly Bacteria Found In Mainland Us Soil For First Time Already Linked To Two Cases" are also interested in: DEADLY Definition & Meaning, DEADLY definition and meaning.
Visual Analysis
Data Feed: 8 UnitsIntelligence Data
deadly, mortal, fatal, lethal mean causing or capable of causing death. deadly applies to an established or very likely cause of death.
Add to word list dangerous and able to kill: a deadly poison (Definition of deadly from the Cambridge Academic Content Dictionary © Cambridge University Press)
1. causing or tending to cause death; lethal. 2. aiming to kill or destroy; implacable: a deadly enemy. 3. like death. 4. excruciatingly boring. 5. excessive; inordinate: deadly haste.
DEADLY definition: causing or tending to cause death; fatal; lethal. See examples of deadly used in a sentence.
Synonyms: deathly, fatal, lethal, mortal, killer, more... Collocations: a deadly [virus, illness], a deadly attack on [Paris], the deadly attack on [Monday], more...
Dec 22, 2016 · If you describe a person or their behaviour as deadly, you mean that they will do or say anything to get what they want, without caring about other people.
Dec 21, 2025 · deadly (comparative deadlier or more deadly, superlative deadliest or most deadly) (obsolete, rare) Subject to death; mortal. quotations
Helpful Intelligence?
Our AI expert system uses your verification to refine future results for Deadly Bacteria Found In Mainland Us Soil For First Time Already Linked To Two Cases.